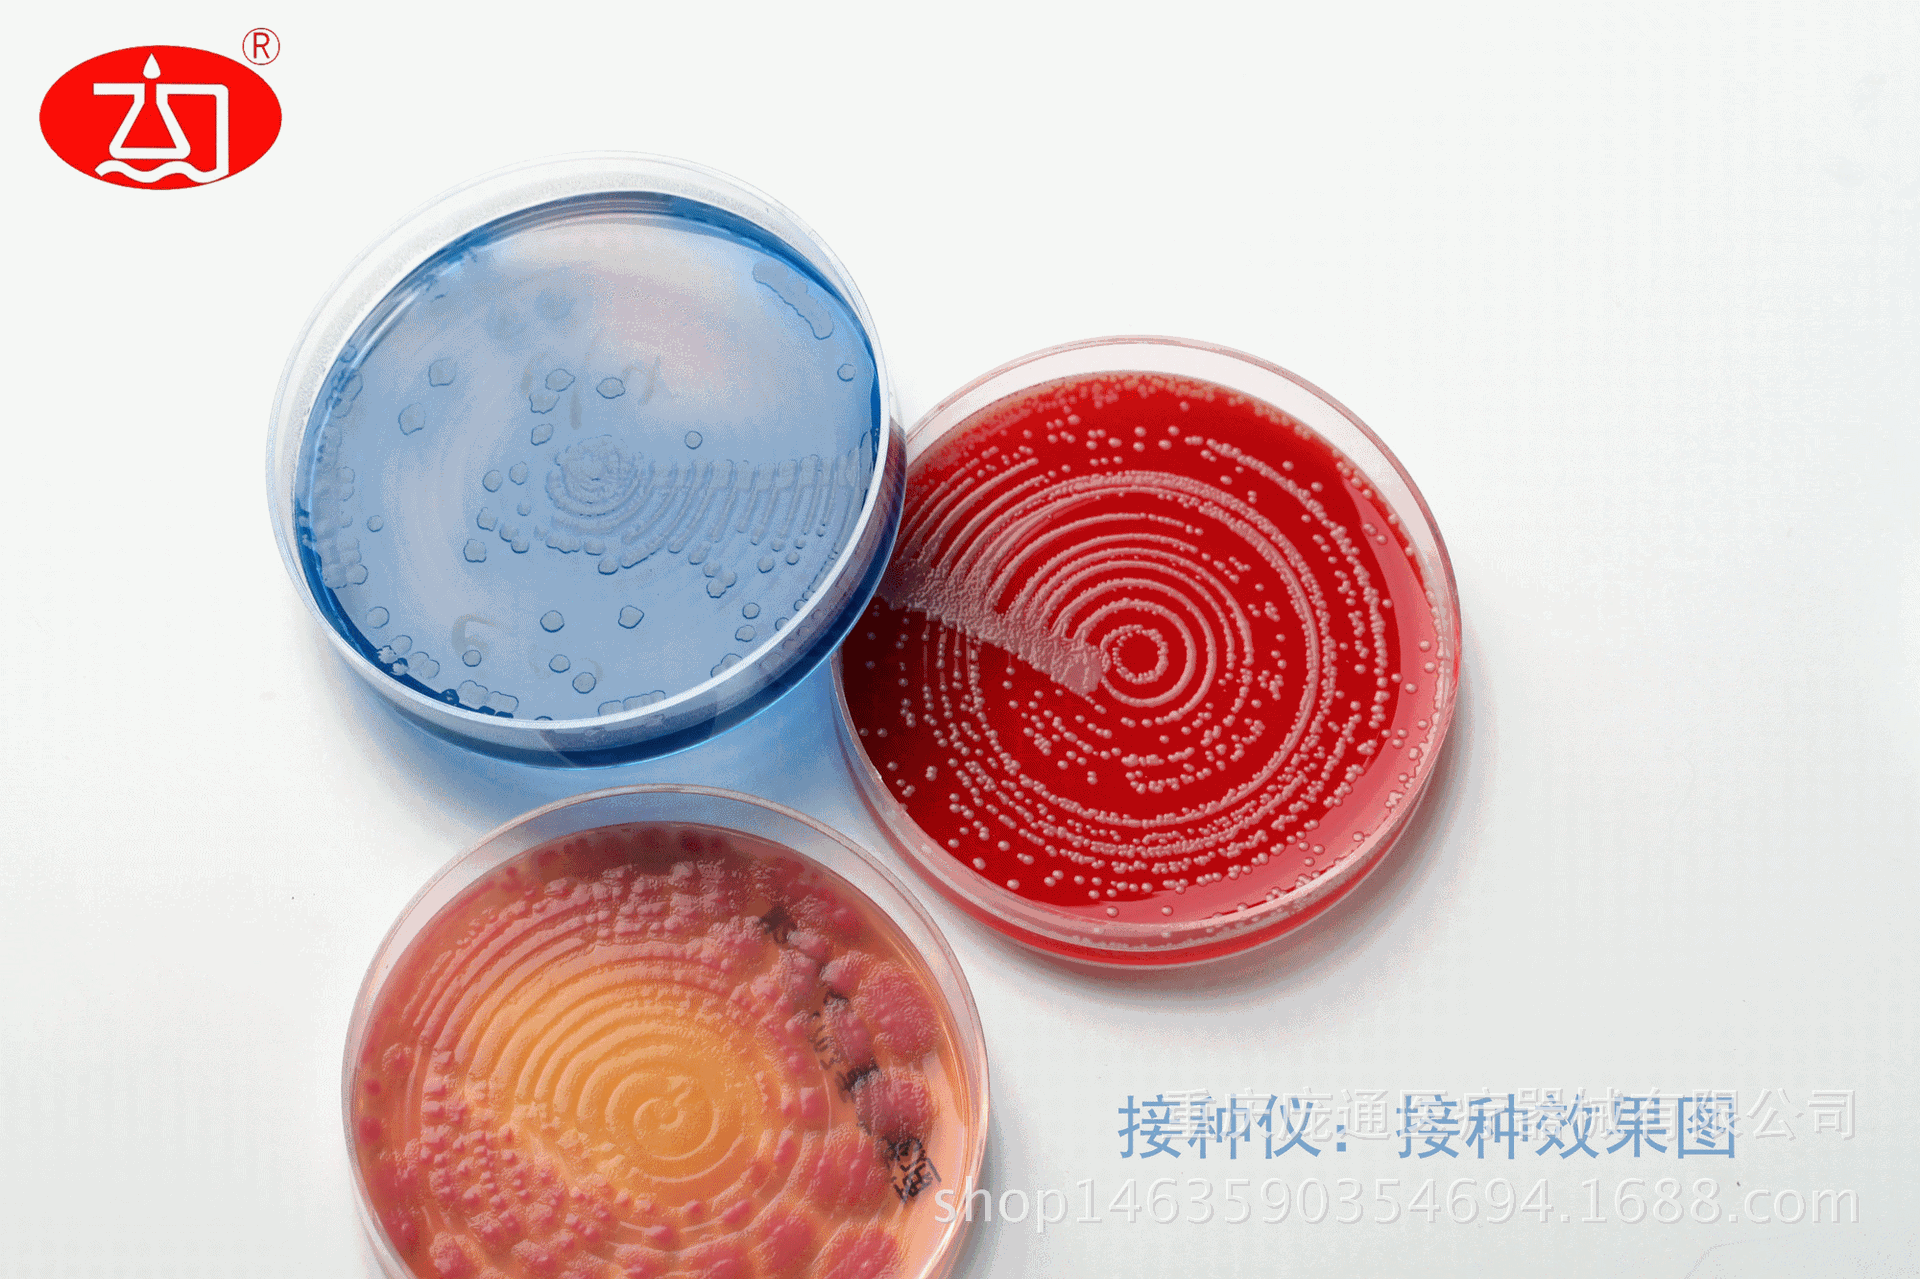
哥伦比亚血琼脂培养基 血琼脂平板 血平皿 专业成品培养基
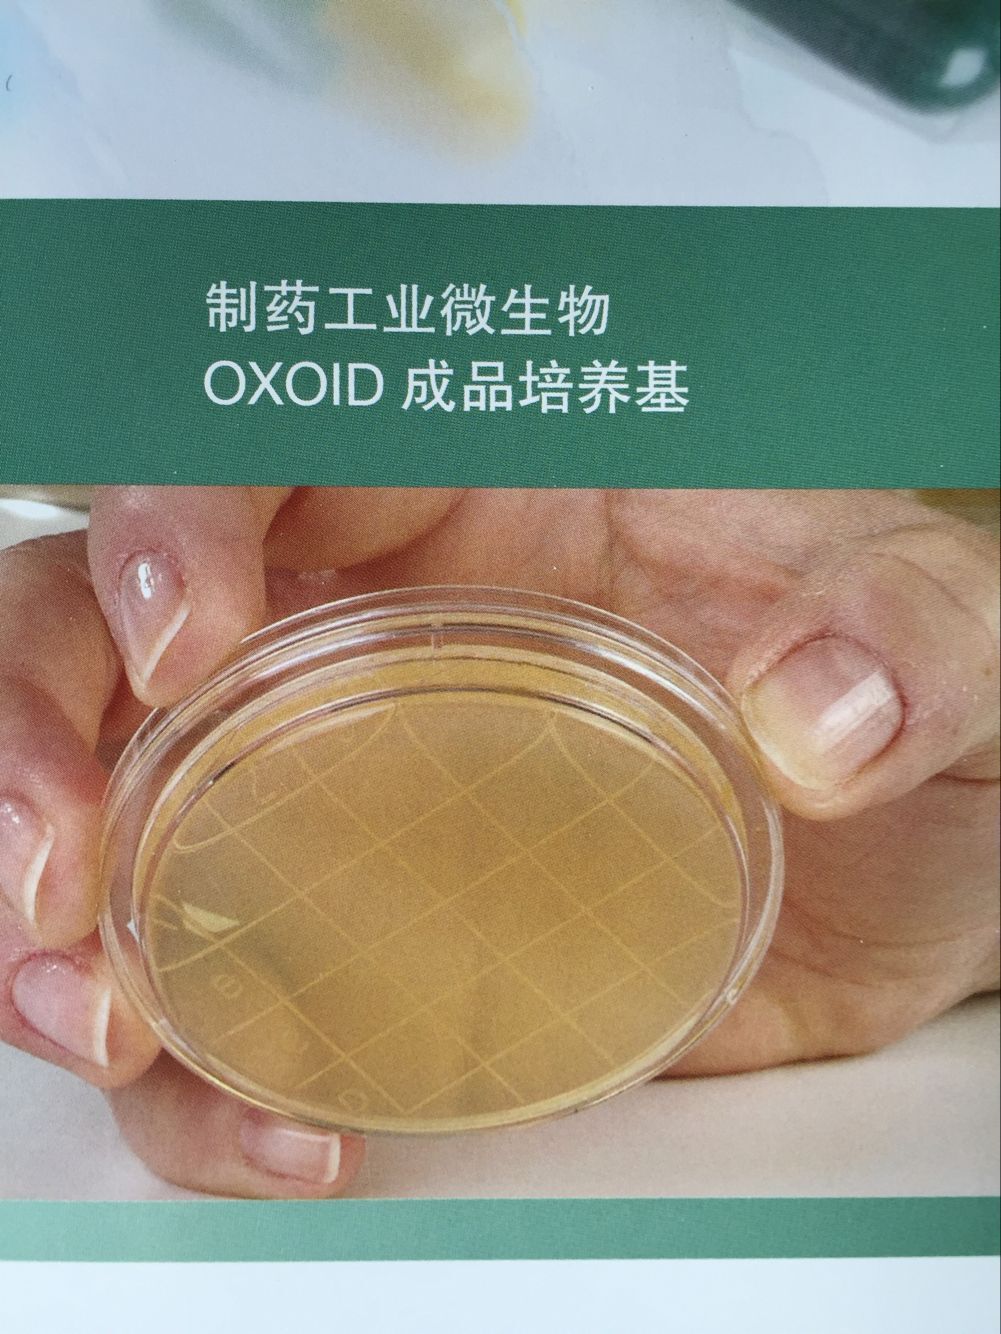
oxoid成品培养基制药行业微生物常用辐照平板

成品培养基

cp0220mh琼脂培养基平板即用成品90mm
图片尺寸2104x2271
瑞楚生物rebio 沙氏葡萄糖琼脂培养基 沙氏琼脂 sda 预装培养基 成品
图片尺寸800x800
瑞楚生物rebio 沙氏葡萄糖琼脂培养基 沙氏琼脂 sda 预装培养基 成品
图片尺寸1920x1920
血平板一次性成品培养基9cm
图片尺寸743x708
液体培养基基础
图片尺寸2983x1584
血平板(成品培养基)
图片尺寸800x800
血琼脂平板 成品培养基 90mm*10个 细菌微生物检测 血琼脂平板
图片尺寸800x800
哥伦比亚血琼脂培养基 血琼脂平板 血平皿 专业成品培养基
图片尺寸1920x1279
天然培养基与合成培养基的区别在哪?
图片尺寸2848x1728
培养基
图片尺寸2106x2106
024087-环凯微生物 伊红美蓝琼脂培养基(平板)_一次性成品培养基-广东
图片尺寸1772x1965
双歧杆菌培养基
图片尺寸300x225
90mmbbl 培养基 双歧杆菌检验> 微生物平板 成品培养皿 厂家供应
图片尺寸800x800
实验室培养皿中的培养基
图片尺寸1200x795
细胞培养基的分类与选择技术总结
图片尺寸710x430
血平板(一次性成品培养基)
图片尺寸790x1027
胰酪大豆胨琼脂培养基tsa袋装即用型
图片尺寸1000x1000
oxoid成品培养基制药行业微生物常用辐照平板
图片尺寸1000x1333
ss琼脂培养基疾控中心常用成品培养基 沙门,志贺菌属琼脂平板
图片尺寸1920x1657
支原体固体培养基使用说明
图片尺寸600x600